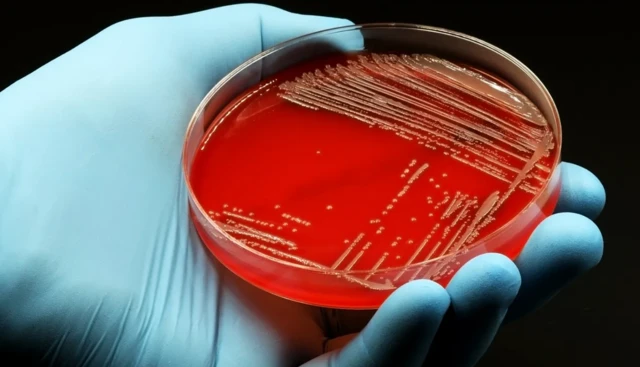
मेडिसिन

एंटीबायोटिक्स लेने के कितने फ़ायदे और कितने नुक़सान, आँत पर क्या पड़ता है असर

इमेज स्रोत, Getty Images
- Author, अंजलि दास
- पदनाम, बीबीसी हिंदी के लिए
माइक्रोऑर्गेनिज़्म यानी सूक्ष्मजीव, जैसे कि बैक्टीरिया, वायरस आदि, इंसानों के पेट में भी पाए जाते या पनपते हैं.
इनमें से कुछ ऐसे भी होते हैं जो इंसानों के लिए मददगार होते हैं. वैसे ही जैसे बैक्टीरिया दूध से दही बनने की प्रक्रिया में सहायक होते हैं.
हमारे शरीर में करोड़ों की संख्या में ऐसे बैक्टीरिया पाए जाते हैं जिनके बग़ैर हम जीवित नहीं रह सकते और इनकी सबसे बड़ी संख्या हमारी आंत में होती है.
गट यानी कि आंत में पाए जाने वाले बैक्टीरिया का हमारे स्वास्थ्य पर बड़ा असर पड़ता है.
यहां तक कि ये इम्यून सिस्टम या प्रतिरोधक क्षमता को अच्छा बनाए रखने और पाचन तंत्र (डाइजेस्टिव सिस्टम) के लिए भी सहायक होते हैं.
हम ये भी जानते हैं कि इंसान की तबीयत बिगड़ने पर कई बार एंटीबायोटिक्स खाने की सलाह दी जाती है.
बीते लगभग 80 सालों से एंटीबायोटिक्स संक्रामक रोगों से सफलतापूर्वक लड़ रहे हैं.
इसकी वजह से दुनियाभर में बीमार होने की दर और बीमारी से मरने वालों की संख्या में कमी आ रही है.
यह एक ऐसी दवा है जो इंसानों और जानवरों का वायरस, बैक्टीरिया आदि से बचाव करती है. इसलिए एंटीबायोटिक्स को मूल रूप से माइक्रोऑर्गेनिज़्म को रोकने वाला एंटीमाइक्रोबियल एजेंट्स कहा जाता है.
जानकार क्या कहते हैं?

इमेज स्रोत, Getty Images
जानकार बताते हैं कि गट माइक्रोबायोम के लिए एंटीबायोटिक्स सबसे बड़ा खतरा हैं.
अमेरिकन सोसाइटी फ़ॉर माइक्रोबायोलॉजी के एमबायो जर्नल में प्रकाशित शोध के मुताबिक 'जब एक इंसान बीमार पड़ता है और डॉक्टर उसे एंटीबायोटिक्स खाने की सलाह देते हैं, तो एंटीबायोटिक्स प्रतिरोध के कारण उस एक सिंगल कोर्स से शरीर में पाए जाने वाले इन माइक्रोऑर्गेनिज़्म पर गंभीर असर पड़ता है और लगभग एक साल के लिए वो पूरी तरह से अस्त व्यस्त हो जाते हैं.'
वैज्ञानिक जर्नल प्रोसिडिंग्स ऑफ़ नैशनल एकेडमिक्स ऑफ़ साइंस में प्रकाशित एक रिसर्च पेपर के मुताबिक़ 2000 और 2015 के बीच पूरी दुनिया में एंटीबायोटिक्स के दिए जाने में 65% वृद्धि हुई है.
एंटीबायोटिक्स पर बढ़ती इस निर्भरता से हमारे स्वास्थ्य पर पड़ते असर को लेकर वैज्ञानिक चिंतित हैं.
एंटीबायोटिक्स दिए जाने में हुई बढ़ोतरी से दो बड़ी समस्याएं पैदा हो रही हैं-
- इससे हमारे गट माइक्रोबायोम्स को नुकसान हो रहा है
- एंटीबायोटिक्स के प्रति बैक्टीरिया की प्रतिरोधक क्षमता बढ़ रही है.
मेडिकल न्यूज़ टुडे की एक रिपोर्ट में बताया गया कि अमेरिका में एंटीबायोटिक्स के प्रति प्रतिरोध की क्षमता बढ़ने की वजह से अस्पतालों में इलाज पर असर पड़ रहा है.
सेंटर ऑफ़ डिज़ीज़ कंट्रोल (सीडीसी) ने अमेरिका में इन दवाओं से प्रतिरोधी खतरों को चिह्नित करते हुए उन्हें तीन कैटेगरी में रखा है- बहुत ज़रूरी, गंभीर या चिंताजनक.
साथ ही स्वास्थ्यकर्मियों से भी एंटीबायोटिक्स के इस्तेमाल को नियंत्रित करने की अपील की गई है.
कई शोध में यह भी दिखा है कि लगातार एंटीबायोटिक्स लेने का शरीर पर गंभीर असर होता है.
“हाई डोज़ से पेट में हुआ असहनीय दर्द”

इमेज स्रोत, Jhanvi Shukla
मध्य प्रदेश के जबलपुर की जाह्नवी शुक्ला के साथ एंटीबायोटिक का ऐसा ही असर हुआ. उन्हें लंबे वक़्त तक हाई डोज़ एंटीबायोटिक्स पर रखा गया था.
उन्होंने बताया, "इसी साल फ़रवरी के महीने में मेरे दोनों पैर के घुटने बदले गए थे. बड़ा ऑपरेशन था तो लंबे समय तक दवाइयां खानी थीं. एंटीबायोटिक्स भी चल रहे थे. आठ-दस दिनों तक सब ठीक था. उसके बाद मेरे पेट में तकलीफ़ हुई और इतना असहनीय दर्द होने लगा कि ऑपरेशन का दर्द मैं पूरी तरह से भूल गई.
"पेट दर्द बहुत परेशान करने लगा. शुरू शुरू में समझ ही नहीं आया कि ये दर्द क्यों हो रहा है. पेट में ऐंठन और असहनीय पीड़ा होती थी."
जाह्नवी शुक्ला ने बताया कि उस दर्द के सिलसिले में वो जब डॉक्टर के पास पहुंची तो उनके एंटीबायोटिक्स के डोज़ को कम किया गया जिससे उनकी समस्या कुछ कम हुई.
वे बताती हैं, "डोज़ कम करने के बाद पेट दर्द में कमी आई लेकिन उस दौरान मैं लगभग एक महीने तक परेशानी रही."
एंटीबायोटिक्स का गट बैक्टीरिया पर असर

इमेज स्रोत, Getty Images
रिटायर्ड गैस्ट्रोइंट्रोलॉजिस्ट डॉक्टर पी. घोष कहते हैं, "एंटीबायोटिक्स का इस्तेमाल तब ही किया जाना चाहिए जब इसके बग़ैर काम न चल रहा हो."
वे कहते हैं, "हम एंटीबायोटिक्स के बग़ैर इलाज नहीं कर सकते, इसमें कोई दो राय नहीं है. लेकिन ऐसी कई परिस्थिति आती है जब हमें इसका इस्तेमाल नहीं करना चाहिए."
साथ ही वे यह भी जानकारी देते हैं कि अलग अलग तरह के गट बैक्टीरिया जितनी बड़ी संख्या में मौजूद रहेंगे, शरीर के लिए उतना ही बेहतर होगा.
डॉ. घोष कहते हैं, "एंटीबायोटिक्स के एक कोर्स से ही उसके (एंटीबायोटिक्स के) प्रति प्रतिरोध पैदा होने का ख़तरा होता है और गट माइक्रोबायोम की आपके आंत में उपस्थिति पर असर पड़ता है. इतना ही नहीं एंटीबायोटिक्स का इस्तेमाल संक्रमण फ़ैलाने वाले जिस बैक्टीरिया को हटाने के लिए किया जाता है, वो उसके अलावा अन्य बैक्टीरिया पर भी हमला कर देता है."
वे कहते हैं, "दरअसल एटीबायोटिक्स आंत के सभी बैक्टीरिया पर असर डालते हैं."
अमेरिका के सैंट लुइस स्थित वाशिंगटन यूनिवर्सिटी स्कूल ऑफ़ मेडिसिन में लैबोरेटरी ऐंड जेनोमिक मेडिसन के प्रोफ़ेसर गौतम डांतास जंगल का उदाहरण देते हुए कहते हैं, "यह कारपेट बम का इस्तेमाल कर के जंगल से एक तिनका निकालने की तरह है. ऐसे में अच्छे और बुरे दोनों तरह की चीज़ें नष्ट होती हैं. एंटीबायोटिक्स ठीक उसी तरह से काम करते हैं."
गट का दिमाग़ से नाता
इमेज स्रोत, Getty Images
गट एक लंबी ट्यूब है जो मुंह से शुरू हो कर मलद्वार (एनस) तक जाती है. इसमें करोड़ों की संख्या में बैक्टीरिया और अन्य परजीवी रहते हैं जिन्हें माइक्रोबायोम कहा जाता है.
मेडिकल एक्सपर्ट के मुताबिक़ गट और दिमाग़ दोनों एक दूसरे से जुड़े हैं. और हम जानते ही हैं कि हमारा दिमाग़ पूरे शरीर को संदेश भेजता है. उसी तरह गट भी दिमाग़ के साथ संवाद कर सकता है.
हावर्ड हेल्थ पब्लिशिंग की एक स्टडी के अनुसार अगर गट को कोई परेशानी होती है तो उसका सीधा सिग्नल दिमाग़ में जाता है और ऐसे ही जब दिमाग़ में परेशानी होने पर गट वो गट को सिग्नल भेज सकता है. ऐसा इसलिए है क्योंकि ब्रेन और गट दोनों आपस में कनेक्टेड हैं.
किसी को गट की समस्या है इसके कई लक्षण हो सकते हैं जैसे-
- किसी काम से बार बार ध्यान का भटकना
- कमज़ोर याददाश्त
- तनाव
- चिंता आदि.

इमेज स्रोत, Getty Images
गट की समस्या जिन अन्य चीज़ों को प्रभावित करता है उनमें स्किन, इम्यून सिस्टम, अनियमित ब्लड शुगर, मेटाबोलिज़्म आदि भी शामिल हैं.
इम्पीरियल कॉलेज लंदन में कंसल्टेंट सर्जन जेम्स किनरॉस कहते हैं, "सबसे बेहतर तो ये है कि एंटीबायोटिक्स पर निर्भर ही नहीं रहा जाए. हमारे शरीर के अंदर ही बीमारियों को ठीक करने की क्षमता भी है. हम अपने शरीर की इकोलॉजी को खान पान से दुरुस्त कर सकते हैं. इसलिए अपने शुरुआती जीवन में हमें स्वस्थ खान पान पर पूरा ध्यान देना चाहिए."
इसकी मूल कहानी पढ़ने के लिए इस लिंक पर क्लिक करें.
(बीबीसी हिन्दी के एंड्रॉएड ऐप के लिए आप यहां क्लिक कर सकते हैं. आप हमें फ़ेसबुक, ट्विटर, इंस्टाग्राम और यूट्यूब पर फ़ॉलो भी कर सकते हैं.)












